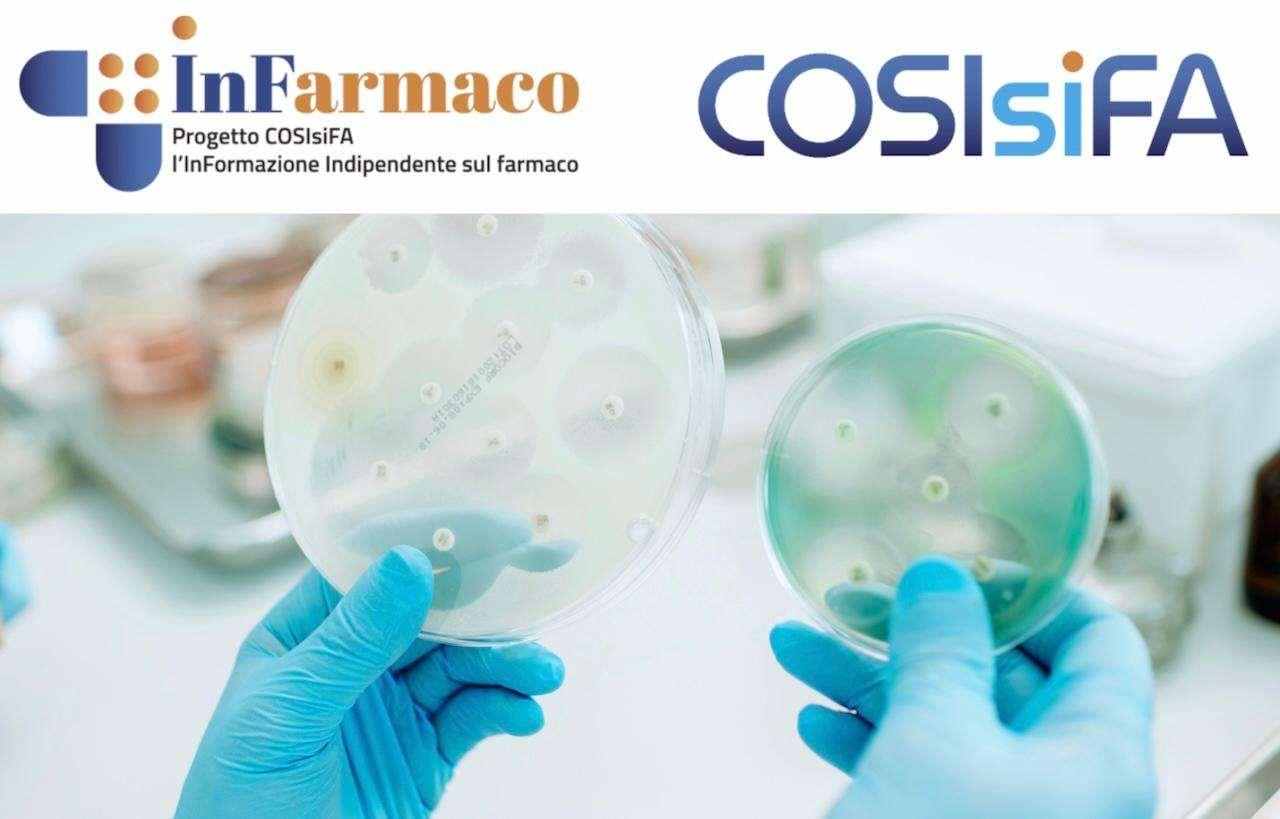
Corso FAD da 12 crediti ECM

L'aumento globale delle resistenze batteriche rappresenta una delle sfide più critiche per la sanità moderna. Per rispondere a questa emergenza, il Provider Nazionale ECM Zadig n. 103 ha lanciato il corso FAD 12 crediti ECM "Uso appropriato degli antibiotici (con approfondimenti EBM)", un percorso formativo indipendente e privo di sponsorizzazioni commerciali.
Il corso è disponibile online dal 1° gennaio al 31 dicembre 2026, salvo esaurimento posti, per cui iscriversi solo se realmente intenzionati a svolgere il corso.
Obiettivi e destinatari
Il programma è rivolto a tutti gli operatori sanitari e mira a fornire strumenti pratici per promuovere l'appropriatezza prescrittiva e la sicurezza nell'uso dei farmaci antibiotici.
Al termine del percorso, i partecipanti avranno acquisito competenze avanzate in:
- Analisi critica della letteratura: valutazione di validità e trasferibilità degli studi clinici.
- Evidence Based Medicine (EBM): lettura consapevole di linee guida e metanalisi.
- Strumenti Digitali: utilizzo di app dedicate come Firstline e analisi di casi clinici guidati.
- Trasferimento delle conoscenze: capacità di agire come facilitatori a livello locale attraverso l'uso di slide kit strutturati.
Informazioni tecniche e scientifiche
- Periodo di svolgimento: dal 1° gennaio al 31 dicembre 2026
- Destinatari: tutti gli operatori sanitari
- Non è prevista nessuna quota di partecipazione
- Responsabile Scientifico: Giulio Formoso, Direttore S.C. Farmacoepidemiologia dell'Azienda USL di Reggio Emilia.
- Docenti: Il corpo docente include esperti di fama nazionale provenienti da prestigiose università e dal Centro Cochrane Italiano.
- Metodologia didattica: Video-presentazioni seguite da questionari di valutazione per ogni modulo.
Struttura del corso
Il percorso formativo ha una durata di 12 ore, eroga 12 crediti ECM ed è suddiviso in 4 moduli propedeutici:
Modulo 1: epidemiologia e studi clinici
Si analizza il contesto epidemiologico globale e la classificazione AWARE dell'OMS. Vengono introdotti i concetti di studi osservazionali e randomizzati (RCT), con un focus particolare sulle infezioni delle vie aeree superiori negli adulti e in pediatria.
Modulo 2: revisioni sistematiche e metanalisi
Questo modulo approfondisce la metodologia della ricerca, concentrandosi sui trial di non inferiorità (utilizzati per dimostrare che un trattamento "non è peggio" di quello standard) e sulla lettura guidata di revisioni sistematiche del Centro Cochrane Italiano.
Modulo 3: Linee Guida e metodo GRADE
Viene illustrato il metodo GRADE per la graduazione delle raccomandazioni cliniche. La formazione prosegue con l'uso pratico dell'app Firstline e l'analisi di casi clinici reali per adulti e bambini.
Modulo 4: formazione "a cascata"
L'ultimo modulo è dedicato alla discussione e alla presentazione di uno slide kit. I partecipanti potranno utilizzare queste diapositive per organizzare incontri formativi locali, facilitando il trasferimento delle conoscenze sull'appropriatezza prescrittiva ai propri colleghi.